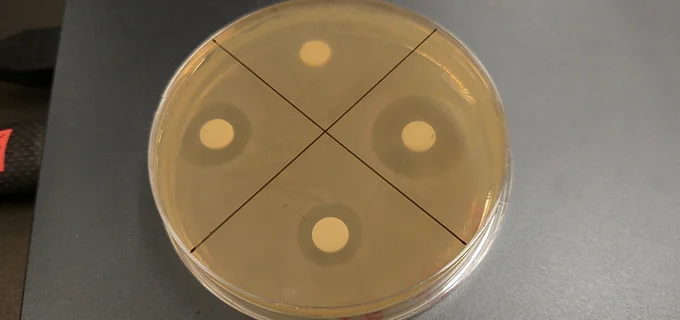

多くの人の命を救ってきた「ペニシリン」は偶然の産物だった⁉
公開
更新
読みものランキング
-
 1位
1位「知らない話が始まった…」3人組ママ友の気まずい時間/ママ友トライアングル(1)
-
 2位
2位小5の夏に経験した親友の失踪。20年後に出会ったのは、彼女にそっくりな女性で/その叫びは聞こえていたのに(1)
-
 3位
3位「うちの子に限って」いじめへの関与なんて絶対ありえないと思っていたのに/娘がいじめをしていました(1)
-
 4位
4位笑顔も何もかも嘘だったんだ。いじめられていたことを4年間隠し続けていた娘/家族全員でいじめと戦うということ。(1)
-
 5位
5位お尻から大量出血でトイレがすごいことに!病院を後回しにしていたら…/痔だと思ったら大腸がんステージ4でした(1)
読みものランキングをもっと見る
おすすめ読みもの(PR)
レシピランキング
レシピランキングをもっと見る